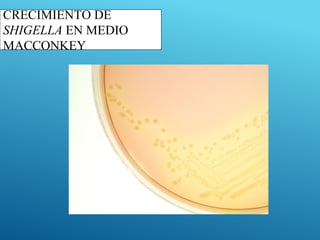
CRECIMIENTO DE
SHIGELLA EN MEDIO
MACCONKEY
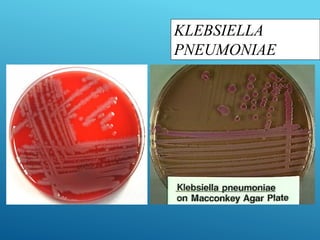
KLEBSIELLA
PNEUMONIAE

Este documento describe las características de las especies de Escherichia coli patógenas. Explica que E. coli puede clasificarse en cinco grupos principales según sus factores de virulencia y manifestaciones clínicas. Describe cada grupo y proporciona detalles sobre sus mecanismos de patogenicidad, síntomas clínicos y epidemiología. El documento también cubre temas como la estructura antigénica, diagnóstico de laboratorio y Salmonella como otra enterobacteria patógena.